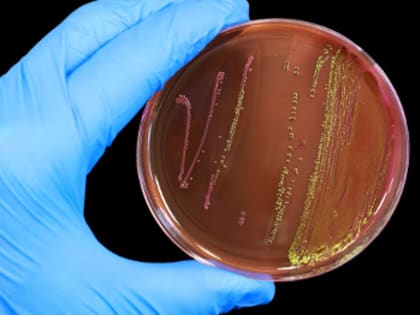

Здоровье

Опасные спутники наркомании
Употребление наркотиков опасно не только для психического и физического здоровья, но и повышает риск заражения серьёзными инфекциями.Чем можно заразиться?

История с липовой диспансеризацией в архангельских больницах набирает обороты
Сегодня правоохранители нагрянули в плесецкую райбольницу. Визит силовиков связан с возможной фиктивной диспансеризацией в медучреждении.

Метеозависимые, держитесь: когда магнитные бури в феврале 2025 года
Полный календарь потенциально опасных дат Если вы ни с того ни с сего теряете аппетит, не хотите никуда выходить, да и просто с кровати встать не можете, не исключено, что вы попали в ловушку магнитных бурь.

Специалисты Онежской больницы используют высокотехнологичные методы для лечения пациентов
В 2024 году хирурги Онежской ЦРБ внедрили в работу несколько новых направлений – в медучреждении начали делать операции по исправлению вальгусной деформации стопы и при болезни Нотта.

Синоптики обещают снег и ветер в Поморье
Температура воздуха будет колебаться от +2 до -3 градусов Фото: PxHere© По данным Северного УГМС, 30 января, в регионе ожидается облачная с прояснениями погода.

О результатах надзора за приостановлением реализации алкогольной, пищевой и непищевой спиртосодержащей продукции. Статистика алкогольных отравлений
О результатах надзора за приостановлением реализации алкогольной, пищевой и непищевой спиртосодержащей продукции.

Проклятое место: в Архангельске на три месяца из-за заразы в еде прикрыли «Арарат»
На 90 суток приостановлена деятельность ресторана «Арарат» за нарушение требований санитарно-эпидемиологического законодательства.

На 90 суток приостановлена деятельность организации общественного питания за нарушение требований санитарно-эпидемиологического законодательства
По результатам проведенной специалистами Управления Роспотребнадзора по Архангельской области плановой проверки ресторана «Арарат», расположенного на дебаркадере по адресу: г. Архангельск, Набережная Северной Двины, 82,
В архангельском ресторане «Арарат» обнаружили кишечную палочку
Решением Ломоносовского суда Архангельска на 90 суток приостановлена деятельность ресторана «Арарат».

Как быстро наркотики вызывают зависимость?
Главный внештатный психиатр-нарколог миниздрава Архангельской области Анна Еремеева объясняет, от чего это зависит и почему не стоит даже пробовать.